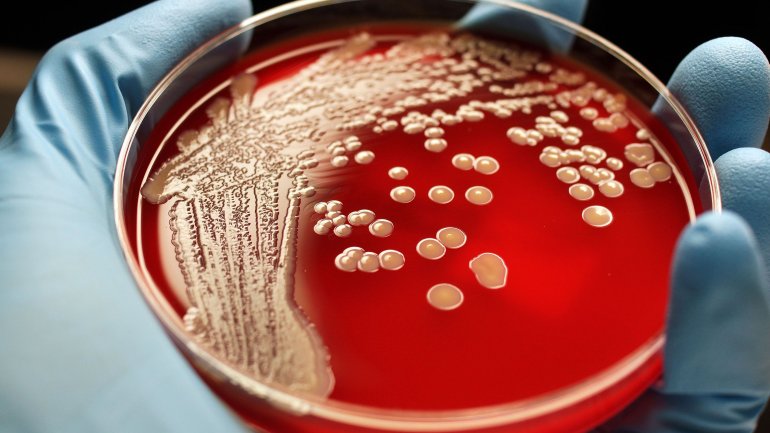

Θάνος Ξυδόπουλος
Περίπου το 5% των νοσοκομειακών ασθενών έχουν MRSA (Μethicillin Resistant Staphylococcus aureus: χρυσίζων σταφυλόκοκκος ανθεκτικός στη μεθικιλλίνη) στο δέρμα τους ή στις μύτες τους, έχοντας έτσι υψηλό κίνδυνο εμφάνισης λοίμωξης ενώ αναρρώνουν από ασθένεια ή εγχείρηση.
Τα βήματα υγιεινής που δοκιμάστηκαν από τους ερευνητές μείωσαν αυτόν τον κίνδυνο σχεδόν κατά το ένα τρίτο. «Είναι μια πολύ απλή λύση. Δεν χρειάζεται να καταπιείτε κάποιο φάρμακο, απλά πρέπει να καθαρίζετε το εξωτερικό του σώματός σας για λίγο περισσότερο», δήλωσε η Δρ. Susan Huang από το University of California Irvine School of Medicine.
Η μελέτη περιελάμβανε περισσότερους από 2.000 ασθενείς σε νοσοκομεία της Νότιας Καλιφόρνιας που βρέθηκαν να φέρουν MRSA. Όλοι έλαβαν πληροφορίες για τρόπους αποφυγής της μόλυνσης και οι μισοί έλαβαν ειδικά προϊόντα – στοματικό διάλυμα, υγρό σαπούνι που περιείχε αντισηπτικό και αντιβιοτική αλοιφή για τη μύτη. Τους δόθηκε η συμβουλή να τα χρησιμοποιούν από Δευτέρα μέχρι Παρασκευή, κάθε δεύτερη εβδομάδα για έξι μήνες.
Ένα χρόνο αργότερα, το 6% των ασθενών που έκαναν αυτή τη θεραπεία ανέπτυξαν λοίμωξη με MRSA έναντι 9% των άλλων. Είχαν επίσης λιγότερες λοιμώξεις από άλλα μικρόβια.
Αντισηπτική θεραπεία
«Πολλοί άνθρωποι μπορεί να πιστεύουν ότι αισθάνονται καλά και δεν χρειάζεται πραγματικά να κάνουν μια τέτοια θεραπεία», δήλωσε ο Δρ. John Jernigan από τα Κέντρα Ελέγχου και Πρόληψης Νοσημάτων των ΗΠΑ αλλά «ο κίνδυνος δεν τελειώνει όταν πάτε σπίτι».
Το αντισηπτικό σαπούνι ήταν ένα διάλυμα 4% χλωρεξιδίνης που πωλείται σε πολλά φαρμακεία.
«Τα άλλα σαπούνια, ακόμη και αυτά που έχουν χαρακτηριστεί αντιβακτηριακά, μπορεί να μην έχουν τα δραστικά συστατικά για την απομάκρυνση του MRSA», δήλωσε ο Δρ. Robert Weinstein, επικεφαλής της μελέτης και ειδικός στα μολυσματικά νοσήματα στο Cook County Health and Rush University Medical Center, στο Σικάγο. Και πρόσθεσε ότι αξίζει για τον τον ασθενή να κάνει ό, τι μπορεί για να αποτρέψει μια λοίμωξη από MRSA.
Η μελέτη δημοσιεύθηκε στο New England Journal of Medicine.

